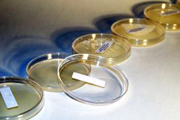

Tamamen siyah ve topuklu ayakkabılarla çarpıcı porn ilk zamanlayıcı paylaşılan eş Cassie Del Isla kamyonundan atlar ve kiralık Bradin sikiş evi için aygırına doğru yol alır. Brad sabırla üst katta bekler ve biraz erken porno olmasına biraz şaşırır ama tatlı sıcak evli amını tatmaya heveslidir porno gif Cassienin tek bir isteği vardı bunu güzel ve yavaş yapmaları böylece başka bir adamla porno fotoğrafları ve onun güçlü zonklayan büyük sikuyla olmanın her parçasının tadını çıkarabilirdi amatör pornolar Cassie Bradin etinin her santimini yaladı ve emdi olağanüstü bir vuruş için porno hikayeleri çok sıkı ve çok ıslak amının içine kaydırmadan önce ve güzel yüzünün ve süper sikiş güzel göğüslerinin her yerinde sağlıklı bir kalın dozda sik kremi patlaması için bazı güzel şehvetli anal.
AltAssets has been serving the global private equity industry for over a decade and has become established as a trusted source of independent news and views on the industry by thousands of professionals worldwide.
Contact us: customerservice@altassets.net
Content is © AltAssets 2000-2020